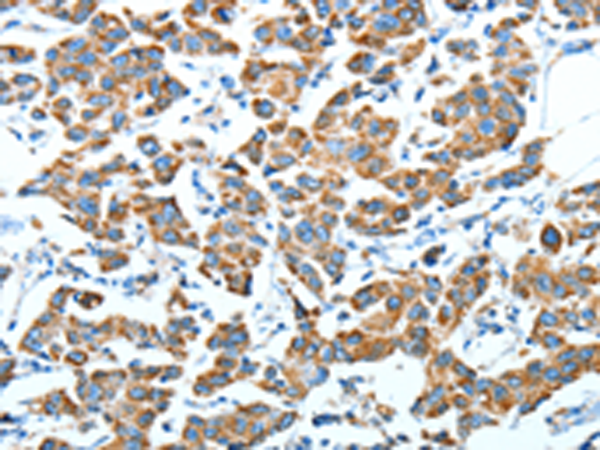
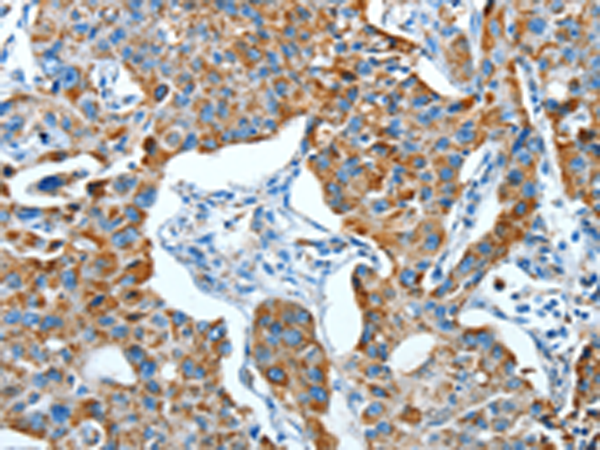

-
分类: 科研抗体货号: P07818别名: CDG1L; DIBD1; LOH11CR1J应用: IHC反应种属: Human, Mouse
-
分类: 科研抗体货号: P07838别名: ALI1; DEGA; AMIGO-2应用: WB,IHC反应种属: Human, Mouse, Rat
-
分类: 科研抗体货号: P07817别名: CDG1G; ECM39; hALG12; PP14673应用: IHC反应种属: Human, Mouse
-
分类: 科研抗体货号: P07837别名: CGI-14应用: WB,IHC反应种属: Human, Mouse, Rat
-
分类: 科研抗体货号: P07816别名: ALDH12; DJ352A20.2应用: WB,IHC反应种属: Human, Mouse
-
分类: 科研抗体货号: P07836别名: DCAF3; WDR94应用: IHC反应种属: Human, Mouse
-
分类: 科研抗体货号: P07815别名: MMSDH; MMSADHA应用: WB,IHC反应种属: Human, Mouse, Rat
-
分类: 科研抗体货号: P07835别名: ALS2CR11应用: IHC反应种属: Human
-
分类: 科研抗体货号: P07814别名: P5CD; ALDH4; P5C应用: WB,IHC反应种属: Human, Mouse, Rat
-
分类: 科研抗体货号: P07834别名: PAPK; ILPIP; ILPIPA; ALS2CR2; CALS-21; PRO1038应用: WB,IHC反应种属: Human, Mouse

鄂公网安备42018502007531号
鄂公网安备42018502007531号

